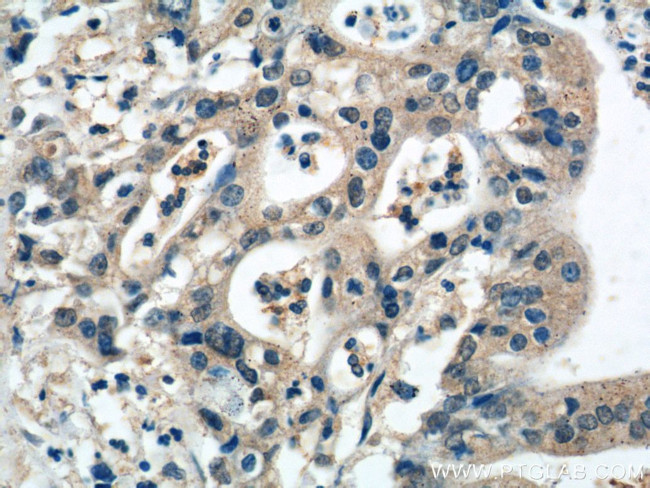
MIA Antibody in Immunohistochemistry (Paraffin) (IHC (P))

Search
Proteintech
MIA Polyclonal Antibody
{{$productOrderCtrl.translations['antibody.pdp.commerceCard.promotion.promotions']}}
{{$productOrderCtrl.translations['antibody.pdp.commerceCard.promotion.viewpromo']}}
{{$productOrderCtrl.translations['antibody.pdp.commerceCard.promotion.promocode']}}: {{promo.promoCode}} {{promo.promoTitle}} {{promo.promoDescription}}. {{$productOrderCtrl.translations['antibody.pdp.commerceCard.promotion.learnmore']}}
产品信息
15734-1-AP
种属反应
宿主/亚型
分类
类型
抗原
偶联物
形式
浓度
纯化类型
保存液
内含物
保存条件
运输条件
产品详细信息
Immunogen sequence: GGPMPKLAD RKLCADQECS HPISMAVALQ DYMAPDCRFL TIHRGQVVYV FSKLKGRGRL FWGGSVQGDY YGDLAARLGY FPSSIVREDQ TLKPGKVDVK TDKWDFYCQ (24-131 aa encoded by BC005910)
靶标信息
Tumorigenesis is a process that is mediated by a network of membrane, cytosolic and nuclear associated factors, which regulate proliferation and cell-matrix interaction through signaling cascades. The phenotype of malignant melanomas in vivo depends on the global expression of stimulatory or inhibitory factors generated in both the tumors cells and their environment. One example, Melanoma inhibitory activity (cartilage-derived retinoic acid-sensitive protein (CD-RAP), MIA) is a Src homology 3 (SH3)-like domain containing protein that is secreted from chondrocytes and malignant melanoma cells. MIA is translated as a 131-amino acid pro-form and processed into a mature 107-amino acid protein after cleavage of a secretion signal. MIA is expressed during chondrogenesis and in mature chondrocytes, suggesting that MIA is necessary for normal cartilage cell phenotype. MIA mRNA is present in carcinomas of the colon, ovary, kidney, and head/neck, and may represent a marker to monitor melanomic activity.
仅用于科研。不用于诊断过程。未经明确授权不得转售。
生物信息学
蛋白别名: cartilage derived retinoic acid sensitive protein; Cartilage-derived retinoic acid-sensitive protein; CD-RAP; melanoma inhibitory activity; melanoma inhibitory activity 1; Melanoma inhibitory activity protein; melanoma inhibitory activity/condrocyte-derived retinoic acid sensitive protein homolog (MIA/CD-RAP); Melanoma-derived growth regulatory protein; melanoma-inhibitory-activity; MIA
基因别名: CD-RAP; Cdrap; MIA; MIA1
UniProt ID: (Human) Q16674, (Mouse) Q61865, (Rat) Q62946
Entrez Gene ID: (Human) 8190, (Mouse) 12587, (Rat) 81510